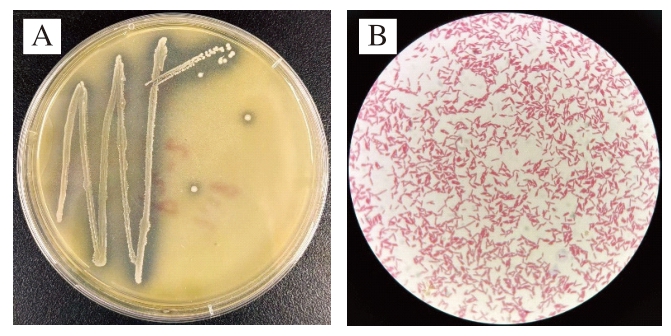

Isolation and Identification of Gluconobacter cerinus in Honey and Its in Vitro Alcohol Utilization Ability
侯宇婷, 高西贝, 张羽, 等. 蜂蜜中蜡状葡糖杆菌分离鉴定及其体外解酒能力[J]. 食品科学, 2025, 46(13): 105-114.DOI:10.7506/spkx1002-6630-20240927-209. http://www.spkx.net.cn
HOU Yuting, GAO Xibei, ZHANG Yu, et al. Isolation and identification of Gluconobacter cerinus in honey and its in vitro alcohol utilization ability[J]. Food Science, 2025, 46(13): 105-114. (in Chinese with English abstract) DOI:10.7506/spkx1002-6630-20240927-209. http://www.spkx.net.cn
过量饮酒会对人的身体带来很大伤害,如引发肝脏损伤、心血管疾病、免疫系统受损等健康问题[1]。《中国药典》中记载,蜂蜜具有解痛止毒的功效,也有文献表示蜂蜜能够促进乙醇的分解吸收,缓解酒后头痛[2]。梁璐璐等[3]通过对急性酒精中毒大鼠喂食蜂蜜,发现蜂蜜具有较好的解酒作用。柯剑[4]研究表明蜂蜜可以增强乙醇脱氢酶和乙醛脱氢酶活性,从而提高乙醇在人体内代谢速度。吴萌等[5]对食品中解酒成分研究发现许多解酒饮品中添加了蜂蜜成分。姜欣欣[6]研究发现,通过给乙醇灌胃的小鼠添加木葡糖醋杆菌可以有效改善由乙醇引起的肠道菌群紊乱。乙醇会导致小鼠体内乳酸杆菌属的丰度明显降低,添加木葡糖醋杆菌后,能够使乳酸杆菌属的丰度重新升高,从而在一定程度上保护乙醇对肝脏的损伤。Nishiyama等[7]研究发现,当同时摄取含有乙醇脱氢酶和乙醛脱氢酶的醋酸菌粉末与乙醇作用时,能显著降低人体呼出气及血液中的乙醇浓度。清野慧至等[8]通过向已摄入乙醇的小鼠投喂醋酸菌发现,醋酸菌有效地抑制了转氨酶水平的上升和脂质的积聚,并改善了肝脏纤维化的状况,从而达到显著的解酒效果。
蜡状葡糖杆菌也是一种醋酸菌,一个重要的特征是它能够将乙醇氧化成醋酸,根据这一特性可以推断出蜡状葡糖杆菌可能具有良好的解酒功效,可以用于缓解乙醇摄入后对健康产生不良影响[9]。
之前研究多数聚焦于醋酸菌的解酒效果,而从蜂蜜中筛选出蜡状葡糖杆菌的研究甚少,蜡状葡糖杆菌对不同体积分数乙醇利用率的影响更鲜见研究。因此,本实验从蜂蜜中筛选蜡状葡糖杆菌入手,探究蜡状葡糖杆菌对溶液中乙醇浓度的影响,并对其进行全基因组预测,以期为其作为益生菌的潜在应用提供科学依据。
蜂蜜由中国农业科学院蜜蜂研究所蜂场提供。
革兰氏染液、碳酸钙、谷氨酸、琼脂粉、酵母粉、乙醇含量检测试剂盒 北京索莱宝科技有限公司;细菌微量生化反应管 杭州微生物试剂有限公司;瓷珠菌种保存管 青岛海博生物技术有限公司;葡萄糖、氯化钠北京奥博星生物技术有限公司。
实验室自制葡萄糖培养基:1%葡萄糖、1%酵母粉、0.5%谷氨酸、2%琼脂。
改良葡萄糖琼脂培养基:1%葡萄糖、1%酵母粉、0.5%谷氨酸、1%碳酸钙、2%琼脂。
AL104电子分析天平 梅特勒-托利多仪器(上海)有限公司;SW-CJ-1D垂直净化工作台 苏州天创净化设备有限公司;LS-50HD立式压力蒸汽灭菌器 江阴滨江医疗设备有限公司;Milli-Q IQ7000超纯水系统 德国默克公司;HERAcell150恒温培养箱 美国赛默飞世尔科技公司;HZQ-F160恒温振荡培养箱 苏州培英实验设备有限公司;Pro96G聚合酶链式反应(polymerase chain reaction,PCR)扩增仪 杭州秋籁科技有限公司;CX31光学显微镜 日本奥林巴斯有限公司;UV-2550紫外分光光度计 日本岛津实验器材有限公司。
1.3.1 菌株的分离纯化与保存
在无菌条件下,将3 mL蜂蜜加入97 mL灭菌后的葡萄糖液体培养基中,在30 ℃恒温培养48 h,形成蜂蜜菌悬液。用无菌水将蜂蜜菌悬液梯度稀释10—2、10—3、10—4、10—5、10—6 倍,降低菌液的浓度,便于获得单个菌落。稀释后吸取100 μL菌悬液涂布在改良葡萄糖琼脂培养基上,在30 ℃恒温培养24 h。平板中挑取外表呈灰白色或黄白色、表面光滑且周围具有透明溶钙圈的菌落进行下一步观察,选择革兰氏阴性的杆菌,在自制的葡萄糖琼脂培养基上划线,分离纯化3 次以上,直至获得菌落形态特征一致的单菌株。最后将剩余的菌落接入磁珠冻存管中,放置在—80 ℃超低温冰箱中进行冷冻保藏。
1.3.2 菌株的生理生化鉴定
使用培养24 h的菌株,用细菌微量生化反应管进行鉴定。将菌株用接种针挑至生化反应管内(阿拉伯糖、木糖、葡萄糖、乳糖、麦芽糖、甘露醇、甘露糖、枸椽酸盐、接触酶、氧化酶、糖酵解O-F、硫化氢、肌醇、乙酰甲基甲醇V-P、靛基质、尿素),24 h后观察颜色变化,判断结果为阴性或阳性,触酶实验使用一次性接种环;V-P实验需要培养48 h后观察颜色变化,参考《伯杰氏细菌鉴定手册》[10]对菌株种类进行初步鉴定。将保存的菌株划线在葡萄糖琼脂培养基,30 ℃好氧培养24 h,复壮2 次后进行实验。
1.3.3 16S rDNA鉴定
将葡萄糖液体培养基中的菌株经离心机4 000 r/min离心15 min后得到的菌体,用无菌水重复操作洗涤3 次后,收集菌体。根据PCR扩增体系对菌株进行扩增。使用细菌DNA提取试剂盒提取DNA后,取30 ng进行PCR扩增。PCR扩增条件:94 ℃预变性5 min;94 ℃变性30 s、50 ℃复性30 s、72 ℃延伸60 s,30 个循环后,72 ℃修复延伸7 min,于4 ℃终止反应。PCR扩增体系:引物各1 μL、模板3 μL、反应混合物12.5 μL、重蒸水7.5 μL。
1.0 %琼脂糖凝胶电泳检测后,将样品送至奥维森基因科技有限公司进行测序分析。测序完成后,利用美国国立生物技术信息中心(National Center for Biotechnology Information,NCBI)的GenBank数据库资源,通过基本局部比对搜索工具(BLAST)将测序结果与已知序列进行同源性比对。基于比对结果,采用MEGA 7软件构建出系统发育树。
1.3.4 生长特性研究
将菌株接种于100 mL的葡萄糖液体培养基中,混匀调至麦氏浊度为1.00(约108 CFU/mL),30 ℃条件下培养24 h。在600 nm处,每2 h测1 次细菌的光密度(OD600),连续测24 h。以培养时间为横坐标,OD600为纵坐标绘制生长曲线,同时测定pH值。同样,分别在24、27、30、33、36 ℃和39 ℃条件下测量菌株P-2的OD600。
1.3.5 安全性实验
1.3.5.1 溶血实验
根据Deng Liquan等[11]的方法。将菌株平板划线至哥伦比亚血平板培养基上,30 ℃培养24 h,观察菌落周围是否出现溶血现象。菌落周围呈现草绿色区域表示α-溶血;有明显的透明区域则为β-溶血;菌落周围未出现任何特殊现象,则判定为γ-溶血。
1.3.5.2 明胶酶活性实验
在Akamine等[12]的方法的基础上进行适应性调整。将24 h培养的菌株接种至明胶生化管中在30 ℃条件下继续培养48 h。培养完成后将生化管转移至4 ℃环境中静置30 min,观察明胶是否液化。
1.3.5.3 硝酸盐还原及脱羧酶实验
根据许喜林等[13]的方法。用培养24 h的菌体接种至硝酸盐还原及鸟氨酸、赖氨酸脱羧酶生化管中37 ℃培养24 h,观察颜色变化。
1.3.5.4 抗菌药物敏感性实验
根据Liu Wei等[14]的方法,采用K-8(药敏片琼脂扩散法)进行药敏实验。吸取麦氏浊度为0.5的菌悬液涂布于葡萄糖固体培养基表面,干燥后用镊子将抗菌药物纸片贴在培养基表面,30 ℃培养24 h,测量出抗生素药敏试纸的抑菌圈直径,实验重复3 次,抑菌圈直径取平均值。抗菌素包括青霉素、氯霉素、红霉素、头孢曲松、氨苄西林、林可霉素、复方新诺明、庆大霉素、环丙沙星、四环素。
1.3.5.5 自聚集及疏水性
按照白慧慧[15]的方法进行修改,将3 份相同菌液麦氏浊度调至0.5,在600 nm处测定OD值(A),30 ℃培养24 h后,再次测定600 nm处的OD值(B),根据式(1)计算菌株自聚集能力,结果取3 次平均值。自聚集能力通常分为3 个等级:>50%为高等,35%~50%为中等,<35%为低等。
向OD值为A的菌液中添加2 mL二甲苯,振荡混合5 min,37 ℃培养1 h后,测定水相的OD值为B,根据式(1)计算菌株疏水性。
1.3.5.6 耐酸、耐胆盐实验
向含有菌株的3 份葡萄糖液体培养基中分别加入盐酸调节至pH 2、2.5、3,调节溶液麦氏浊度为0.5,在600 nm处测定初始OD值(A),30 ℃培养24 h后,再次测定600 nm处的OD值(B),根据式(2)计算菌株的存活率,结果取3 次平均值。
将含有菌株的3 份葡萄糖液体培养基中分别加入0.3%、0.5%、1%的胆汁酸盐,调节溶液麦氏浊度为0.5,在600 nm处测定初始OD值(A),30 ℃培养24 h后,再次测定600 nm处的OD值(B),根据式(2)计算菌株的存活率,结果取3 次平均值。
1.3.6 菌体制备
将菌株接种于含有葡萄糖的固体培养基上,30 ℃条件下培养24 h。从该培养基中挑选出单一菌落,接种至葡萄糖液体培养基中,在30 ℃环境下培养16 h。培养结束后,将葡萄糖液体培养基置于离心机中,4 000 r/min离心10 min分离出菌体。用无菌水对菌体进行3 次洗涤,并再次离心,最终得到净化并备用的菌体。
1.3.7 蜡状葡糖杆菌体外乙醇利用率研究
乙醇在乙醇氧化酶的催化下氧化产生过氧化氢,过氧化氢被过氧化物酶进一步催化与4-氨基安替比林及偶联酚的反应,促使这两者结合生成一种具有特定颜色的化合物,该化合物在505 nm波长处有明显的特征吸收峰[16]。可通过测量和分析505 nm处吸收峰的变化,判断溶液中乙醇的含量,具体采用乙醇含量检测试剂盒进行测定,根据说明书进行操作,其中空白组加入10 μL蒸馏水,标准组加入10 μL标准品,测定组加入8 mg和16 mg菌株样品。将试剂盒中样品充分混合,测定505 nm处的吸光度(A1),在37 ℃水浴中反应5 min测定吸光度(A2),每0.5 h重复一次。上述实验重复3 次,结果取3 次平均值。根据式(3)、(4)计算乙醇浓度和利用率:
式中:ΔA=A2—A1;2 140为换算数据/(mmol/L);F为稀释倍数。
1.3.8 全基因测序
使用DNA提取试剂盒提取菌株P-2的DNA,送至奥维森基因科技有限公司进行三代Nanopore建库测序[17]。使用circlize对得到的基因信息进行预测分析,与基因本体论(Gene Ontology,GO)、京都基因与基因组百科全书(Kyoto Encyclopedia of Genes and Genomes,KEGG)、蛋白质直系同源簇(Clusters of Orthologous Groups of Proteins,COG)功能注释进行整合,绘制基因组圈图,明确菌株的碳水化合物代谢途径、安全性、益生功能与全基因组之间的内在关联,最后根据菌株FASTA序列,预测其为益生菌的概率[18],充分发挥益生菌功能性,为菌株P-2的后续应用提供科学依据。
使用16S rDNA序列进行测序后,在NCBI数据库中搜索相似序列,并利用MEGA 7软件构建系统发育树。乙醇实验数据结果表示为
,用Origin 2021进行绘图分析。全基因测序结果通过Prokka 1.14.6软件对基因组进行编码基因预测。
经改良葡萄糖琼脂培养基30 ℃恒温好氧培养24 h,多次分离纯化后,从蜂蜜中挑取出21 个周围有白色透明溶钙圈的菌落。菌株P-2菌落水润有光泽、圆形、中心凸起、排列细密、表面灰白色(图1);革兰氏染色结果为阴性,显微镜下观察菌株为直杆状,单个或成对。
图1 菌株P-2的菌落形态(A)和菌体特征(B)
Fig. 1 Colony morphology (A) and bacterial characteristics (B) of strain P-2
菌株P-2的生理生化结果如表1所示。菌株P-2可以发酵阿拉伯糖、木糖、葡萄糖、乳糖、麦芽糖、甘露糖;甘露醇、糖酵解O-F、肌醇和接触酶呈阳性;枸椽酸盐、氧化酶、硫化氢、尿素和乙酰甲基甲醇V-P呈阴性。参照《伯杰氏细菌鉴定手册》和《常见细菌与古菌系统分类鉴定手册》,将菌株P-2初步判定为葡糖杆菌。
表1 菌株生化鉴定结果
Table 1 Biochemical identification of strain P-2

注:+.阳性,—.阴性。
项目结果项目结果阿拉伯糖+接触酶+木糖+氧化酶—葡萄糖+糖酵解O-F+乳糖+硫化氢—麦芽糖+肌醇+甘露醇+乙酰甲基甲醇V-P—甘露糖+靛基质—枸椽酸盐—尿素—
菌株16S rDNA片段PCR扩增产物的凝胶电泳结果见图2。基于16S rDNA序列进行测序分析,通过在NCBI的GenBank数据库中检索相似序列进一步探索其遗传关系。为了更直观地展示这些序列之间的系统发育联系,运用MEGA 7软件构建了一个系统发育树。结果显示,菌株P-2与蜡状葡糖杆菌(Gluconobacter cerinus)的同源性达到100%,确认菌株P-2为蜡状葡糖杆菌(图3)。

图2 菌株P-2的16S rDNA扩增产物电泳
Fig. 2 Electropherogram of 16S rDNA amplification products of strain P-2

图3 基于16S rDNA基因序列的遗传进化树
Fig. 3 Genetic evolution tree based on 16S rDNA gene sequence
菌株P-2在24 h内的生长趋势及产酸情况如图4A所示。菌株的生长速率在5 h之后显著加快,进入对数生长期。在20 h后逐渐放缓,转而进入稳定期,生长量趋于稳定。菌液的pH值自接种后开始持续下降,在最初的0~8 h内,pH值从6.15降低到3.63;在8~20 h内,菌液的pH值有所回升,达到3.92;20 h之后,菌液的pH值变化变得平缓,维持在3.95左右。综上,菌株在接种后的8 h内迅速将pH值降至较低水平,并在14 h左右时,pH值进入一个相对稳定的阶段;同时,菌株的生长量在20 h后趋于稳定,预计在22 h左右达到其最大生长量。


图4 菌株P-2的生长趋势、pH值变化(A)和最佳温度(B)
Fig. 4 Growth curve, pH change (A) and optimal growth temperature (B) of strain P-2
如图4B所示,菌株P-2在20~30 ℃可以生长,20 ℃时,OD600值为0.341,随着温度升高,菌株P-2生长量逐渐上升,生长加快,当温度为30 ℃时,菌株P-2菌体生长最好,OD600达到0.557,当温度高于30 ℃时,随着温度升高,生长变慢,在37 ℃以上,菌株P-2几乎不生长,OD600只有0.1左右,说明菌株P-2不耐高温。表明菌株P-2最适生长温度为30 ℃。
2.5.1 溶血性
溶血素是由细菌产生的毒素,它能够引起溶血作用,会导致细胞膜破坏和细胞溶解[19]。γ-溶血通常表现为在血平板上菌落周围没有透明区域或草绿色区域,菌株P-2展现出γ-溶血特性,这意味着它不会引起红细胞的溶解。基于这一特性,菌株P-2可被初步认定为在溶血性方面较为安全,可以作为益生菌的前体之一(图5)。

图5 菌株P-2溶血结果
Fig. 5 Hemolytic activity of strain P-2
2.5.2 明胶酶活性
明胶酶破坏基底膜,其活性与肿瘤细胞的侵袭和转移密切相关[20]。将培养48 h后的生化管放置于4 ℃条件下30 min,取出观察内容物是否液化。菌株P-2未出现液化现象,内容物不流动,结果为阴性。菌株P-2不液化明胶酶,具有一定安全性(图6)。

图6 液化明胶实验
Fig. 6 Liquefied gelatin experiment
2.5.3 硝酸盐还原及脱羧酶实验
当菌体将硝酸盐转化为亚硝胺时,具有致癌性、致突变性和致畸性[21]。菌株P-2的硝酸盐还原无颜色变化,结果为阴性,不产生硝酸盐还原酶,不会将硝酸盐转化为亚硝酸盐(图7)。

图7 菌株P-2硝酸盐还原实验
Fig. 7 Nitrate reduction test of strain P-2
具有氨基酸脱羧酶活性的菌株可分解氨基酸,并生成CO2和生物胺。生物胺过量会导致高血压、头痛、心悸和呕吐[22]。菌株P-2的鸟氨酸脱羧酶及赖氨酸脱羧酶反应呈阴性(图8)。

图8 氨基酸脱羧酶活性实验
Fig. 8 Amino acid decarboxylase activity test of strain P-2
2.5.4 抗生素药物敏感性实验
检测菌株的耐药性,确保对特定感染的首选药物的敏感性[23]。将培养24 h的平板放置于黑色背景下,利用反射光从平板背面用直尺测量,测量抑菌圈直径,根据表2可知,菌株P-2对四环素、头孢曲松敏感。
表2 菌株P-2对10 种抗生素敏感性测定结果
Table 2 Susceptibility of strain P-2 to 10 antibiotics
药物名称四环素头孢曲松氯霉素庆大霉素复方新诺明氨苄西林青霉素林可霉素环丙沙星红霉素抑菌圈直径/mm25.1221.9110.629.65000000
2.5.5 自聚集及疏水性
强疏水性的细菌与宿主细胞形成强的作用力,从而提高菌株在肠道或其他黏膜表面的黏附能力[24]。菌株P-2在24 h内自聚集能力为82.13%,疏水性为37.74%。这种特性不仅能保证P-2菌株在肠道中的定植,还能增强菌株抑制病原菌定植能力。
2.5.6 耐酸耐胆盐能力
胃酸是人体防御外来微生物的重要屏障,其pH值通常维持在1.5~3.5之间,具有强大的杀菌作用[25]。菌株若要在胃肠道中生存并发挥作用,必须具备耐酸性。在pH 2、2.5、3的培养基下,菌株P-2的存活率分别为37.96%、51.88%、77.96%。
胆盐是胆汁的主要成分,对微生物的脂膜结构具有破坏作用,因此,菌株必须具备一定的胆盐耐受能力才能顺利通过胃肠道并在肠道中定植。在0.3%、0.5%、1%胆汁酸盐培养基中,菌株P-2的存活率分别为88.76%、82.45%、77.63%。
耐酸耐胆盐结果反映出菌株P-2可以在胃肠道中存活。
蜡状葡糖杆菌可以将乙醇氧化成醋酸,加速乙醇转化成醋酸速度[26]。如图9A所示,当溶液中乙醇体积分数为4%时,0.5、1、1.5、2 h时溶液中乙醇浓度分别为407.61、382.14、280.24 mmol/L和254.76 mmol/L。加入8 mg菌株后,0.5、1、1.5、2 h时溶液中乙醇浓度分别为229.29、178.33、25.48 mmol/L和0.00 mmol/L,利用率分别为43.75%、53.33%、90.91%和100%。加入16 mg菌株后,0.5、1、1.5、2 h时溶液中乙醇浓度分别为156.96、63.18、0.00 mmol/L和0.00 mmol/L,利用率分别为61.49%、83.47%、100%和100%。随着菌株加入量增加,溶液中乙醇浓度降低,乙醇利用率增大。

图9 菌株对乙醇的利用效率
Fig. 9 Ethanol utilization rate of strain P-2
由图9B可知,当溶液中乙醇体积分数为20%时,0.5、1、1.5、2 h时溶液中乙醇浓度分别为1 248.33、1 171.90、1 044.52 mmol/L和942.62 mmol/L。加入8 mg菌株后,0.5、1、1.5、2 h时溶液中乙醇浓度分别为942.62、789.76、560.48 mmol/L和433.10 mmol/L,利用率分别为24.49%、32.61%、46.34%和54.05%。加入16 mg菌株后,0.5、1、1.5、2 h时溶液中乙醇浓度分别为793.56、593.81、382.55 mmol/L和212.22 mmol/L,利用率分别为36.43%、49.33%、63.38%和77.49%。
由图9C可知,当溶液中乙醇体积分数为40%时,0.5、1、1.5、2 h时溶液中乙醇浓度分别为2 675、2 471.19、2 318.33 mmol/L和1 961.67 mmol/L。加入8 mg菌株后,0.5、1、1.5、2 h时溶液中乙醇浓度分别为2 267.38、1 808.81、1 273.81 mmol/L和942.62 mmol/L,利用率分别为15.24%、26.8%、45.05%和51.95%。加入16 mg菌株后,0.5、1、1.5、2 h时溶液中乙醇浓度分别为1 942.17、1 306.24、1 003.26 mmol/L和781.11 mmol/L,利用率分别为27.40%、47.14%、56.72%和60.18%。
实验对蜡状葡糖杆菌P-2利用乙醇能力进行了评价。如图10所示,随着菌株P-2含量从8 mg增加到16 mg,对不同体积分数乙醇的利用率逐渐增加,尤其对低体积分数乙醇(4%)具有极好的利用效果,随着时间从0.5 h延长到1.5 h,菌株对乙醇的利用能力也呈上升趋势。由此说明菌株P-2具有较强的利用乙醇作用,含量越高利用效果越好,应进一步分析其全基因组序列,探究其潜在功能并预测其可作为益生菌的能力,为开发解酒产品提供依据。

图10 在0.5(A)、1.5 h(B)时不同菌株添加量对乙醇利用率的影响
Fig. 10 Effects of different amounts of strain P-2 on ethanol utilization after 0.5 (A) and 1.5 h (B) of culture
2.7.1 基因组基本组成
使用Circlize将基因组的不同组件,如染色体、基因、突变位点等以圆形布局的方式展示出来,从而更直观地探索它们之间的位置关系、相对大小以及相互之间的相互作用[27-28]。菌株P-2含有一个环状染色体,基因组大小为3.17 Mb,平均GC相对含量为55.62%(图11)。

图11 菌株P-2基因组圈图
Fig. 11 Genome circle map of strain P-2
2.7.2 全基因组基因功能注释分析
2.7.2.1 GO注释
GO是一个国际标准化的基因功能分类体系[29]。对菌株P-2的全基因组注释进行深入分析,发现它在多个二级功能分类上展现出显著的基因富集现象,特别是在翻译、碳水化合物代谢过程、ATP结合过程中表现出明显优势,同时还具有强大的生物膜形成能力,能够有效地将细菌与外界不利环境隔离,从而保护细菌免受外界干扰和潜在威胁(图12)。

图12 菌株P-2的GO数据库细胞组件注释图
Fig. 12 GO annotation analysis of strain P-2
2.7.2.2 KEGG注释
KEGG是一个整合了基因组、化学和系统功能信息的数据库资源[30]。菌株P-2功能丰富,拥有2 396 个注释,其中参与代谢的基因最多,为1 862 个(77.71%)(图13)。说明菌株P-2具有较强的代谢能力,与GO功能注释的结果一致。

图13 菌株P-2基因组的KEGG功能注释
Fig. 13 KEGG functional annotation of strain P-2
2.7.2.3 毒力因子基因注释结果
菌株P-2中注释出了806 个毒力因子,大部分BLAST比对结果均大于50%。在菌株P-2的基因组中,没有检测到氨基酸脱酸酶的完整基因组,表示菌株P-2没有完整的生物胺成基因簇,没有生物胺产生活性。在VFDB数据库中也没有检测出于溶血素、硝基还原酶相关的基因。结合2.5.1~2.5.3节实验结果,菌株P-2不会产生有害代谢物,不具有毒性和致病性。
2.7.2.4 COG注释
COG是一个蛋白质功能分类系统,它根据蛋白质序列的相似性将蛋白质分为不同的组,这些组代表了来自不同物种但具有共同祖先的蛋白质家族[31]。菌株P-2共获得2 976 个COG注释,其中与转运代谢相关的基因数量最多(43.15%),可见菌株P-2具有较强的转运代谢能力(图14)。

图14 菌株P-2基因组的COG功能注释
Fig. 14 COG functional annotation of strain P-2
2.7.2.5 自聚集能力
细胞壁/膜/包膜生物相关蛋白的基因在细菌细胞壁、细胞膜和外层包膜的形成中发挥重要作用,从而影响到菌株的自聚集能力[32]。在COG注释中,菌株P-2的细胞壁/膜/包膜生物相关蛋白的基因编码有275 个(图14),占比较高,结合2.7.2.1节结果,菌株P-2具有强大的生物膜形成能力,同时结合2.5.5节实验结果,证明菌株P-2具有良好的自聚集能力,有助于菌株在肠道中定植。
2.7.2.6 与乙醇代谢相关的酶
菌株P-2中含有乙醇脱氢酶(1.1.1.1)、脱氢酶辅酶(1.2.1.3)、还原性辅酶(1.2.1.5、1.1.1.2)、醇脱氢酶(1.1.2.8、1.1.5.5),这些酶可以将乙醇转化为乙醛,进一步将乙醛分解为乙酸。菌株P-2中的这6 种酶可以加速乙醇在体内转化速度,提高乙醇的利用率,从而达到解酒的效果(图15)。

图15 菌株P-2中与乙醇代谢相关的酶
Fig. 15 Enzymes associated with ethanol metabolism in strain P-2
2.7.3 益生菌株预测
使用iProbiotics网站,将菌株P-2的FASTA序列进行预测[33]。结果显示菌株P-2为益生菌的可能性高达99%以上,可以确定从蜂蜜中筛选出的醋酸杆菌P-2为益生菌。
本研究从蜂蜜中筛选得到的菌株,经过生理生化鉴定和16S rDNA测序分析,鉴定菌株P-2为蜡状葡糖杆菌,属于葡萄糖杆菌属。蜡状葡糖杆菌P-2不产生溶血素、不降解明胶、不产生亚硝酸盐、不产生过量胺。可以在肠道中定植,在酸性环境和胆盐环境中可以生长存活,对抗生素药物敏感,具有一定安全性。且通过对菌株P-2进行全基因测序和益生菌预测,结果显示菌株P-2为益生菌的概率高达99%以上。
菌株P-2可以持续将乙醇转化为乳酸,并很快完成代谢。同时菌株P-2的全基因组含有乙醇脱氢酶、脱氢酶辅酶、还原性辅酶和醇脱氢酶,因此它在利用转化乙醇方面有一定优势。随着时间延长,菌株P-2利用乙醇的能力也进一步增加,在20 mL乙醇体积分数4%和40%的溶液中加入16 mg菌体,经过1 h,乙醇利用率分别为83.47%和47.14%,经过2 h,乙醇利用率达到100%和60.18%。菌株P-2具有很好的安全性和高效性,在解酒方面具有一定优势。但目前对蜡状葡糖杆菌P-2的安全性与益生功能仅为体外实验研究。下一步将利用此菌株进行动物实验与人体实验,进一步明确蜡状葡糖杆菌P-2解酒机制。本实验为建立新的菌种库、开发蜡状葡糖杆菌解酒饮料和可食用益生菌提供了新思路。
[1] 程妮. 蜂蜜植物源鉴别新方法及其保肝活性研究[D]. 西安: 西北大学, 2015.
[2] 兰祖全. 吃点蜂蜜解酒止痛[J]. 蜜蜂杂志, 2015, 35(5): 32.
[3] 梁璐璐, 王影姣, 金小宝. 蜂蜜对急性酒精中毒大鼠的解酒作用研究[J]. 中国食物与营养, 2015, 21(2): 73-76.
[4] 柯剑. “黄陂荆蜜”的解酒保肝活性与作用机制[D]. 武汉: 华中农业大学, 2017. DOI:10.27158/d.cnki.ghznu.2017.000034.
[5] 吴萌, 包麟, 李倩, 等. 解酒功效成分的作用机制、来源及其在食品中的应用进展[J]. 现代食品, 2022, 28(21): 15-21. DOI:10.16736/j.cnki.cn41-1434/ts.2022.21.005.
[6] 姜欣欣. 木葡糖醋杆菌对酒精肝损伤的保护作用及机制研究[D].西安: 陕西师范大学, 2019. DOI:10.27292/d.cnki.gsxfu.2019.000411.
[7] NISHIYAMA H, WATANABE S, OKUYAMA Y. Effect of acetic acid bacteria containing food on ethanol concentration in expiration and blood while healthy adult males drinking[J]. Journal of New Remedies &Clinics, 2017, 66(3): 250-258.
[8] 清野慧至, 栗原仁, 松冈亮辅, 等. 醋酸菌对C57BL/6J小鼠的酒精性肝损伤的影响研究[J]. 中国酿造, 2018, 37(8): 28-31. DOI:10.11882/j.issn.0254-5071.2018.08.007.
[9] 唐史杰, 陈敏, 尹明雨. 醋酸菌调控肠道菌群以解酒护肝的研究进展[J]. 食品与发酵工业, 2022, 48(4): 301-306. DOI:10.13995/j.cnki.11-1802/ts.028133.
[10] WILLIAMS S T, SHARPE M E. 伯杰氏细菌鉴定手册[M]. 中国科学院微生物研究所翻译组, 译. 北京: 科学出版社, 1984.
[11] DENG L Q, LIU L M, FU T Y, et al. Genome sequence and evaluation of safety and probiotic potential of Lactiplantibacillus plantarum LPJZ-658[J]. Microorganisms, 2023, 11(6): 1620. DOI:10.3390/microorganisms11061620.
[12] AKAMINE I T, MANSOLDO F R P, CARDOSO V S, et al. Hydrolase activities of sourdough microorganisms[J]. Fermentation, 2023, 9(8):703. DOI:10.3390/fermentation9080703.
[13] 许喜林, 赵思博, 郑柳青, 等. 鼠李糖乳杆菌LR-ZB1107-01的培养基优化及益生特性评价[J]. 华南理工大学学报(自然科学版), 2022,50(8): 21-29. DOI:10.12141/j.issn.1000-565X.200437.
[14] LIU W, SONG L Y, SUN W, et al. Distribution of microbes and antimicrobial susceptibility in patients with diabetic foot infections in South China[J]. Frontiers in Endocrinology, 2023, 14: 1113622.DOI:10.3389/fendo.2023.1113622.
[15] 白慧慧. 母乳婴儿源益生菌筛选鉴定及其潜在益生特性研究[D].兰州: 兰州理工大学, 2022. DOI:10.27206/d.cnki.ggsgu.2022.000628.
[16] 王哲, 李冠龙, 刘晓兰. 酶法制备玉米七肽糖基化产物及其对乙醇脱氢酶激活活性的影响研究[J]. 食品安全质量检测学报, 2024,15(2): 28-34. DOI:10.19812/j.cnki.jfsq11-5956/ts.2024.02.004.
[17] SEEMANN T. Prokka: rapid prokaryotic genome annotation[J].Bioinformatics, 2014, 30(14): 2068-2069. DOI:10.1093/bioinformatics/btu153.
[18] 刘真真, 彭楠. 益生菌的应用现状和发展前景[J]. 微生物学报, 2023,63(5): 1863-1887.
[19] ABD AL-WAHID Z H, ABD AL-ABBAS M J. Distribution of hla,hlb, hlgC, hld & cylA hemolysin genes and their alleles in different bacterial species isolated from the variant clinical sources in Basrah[J].Journal of Population Therapeutics and Clinical Pharmacology, 2023,30(3): 180-198. DOI:10.47750/jptcp.2023.30.03.021.
[20] FARINA A R, MACKAY A R. Gelatinase B/MMP-9 in tumour pathogenesis and progression[J]. Cancers, 2014, 6(1): 240-296.DOI:10.3390/cancers6010240.
[21] PAN J X, LIU L L, PAN H P, et al. A feasibility study of metal sulfide (FeS and MnS) on simultaneous denitrification and chromate reduction[J]. Journal of Hazardous Materials, 2022, 424: 127491.DOI:10.1016/j.jhazmat.2021.127491.
[22] RESTUCCIA D, SPIZZIRRI U G, PUOCI F, et al. Accumulation of biogenic amines in foods: hazard identification and control options[M]//RAVISHANKAR RAI V, JAMUNA BAI A. Microbial food safety and preservation techniques. Boca Raton: CRC Press,2014: 72-93. DOI:10.1201/b17465-8.
[23] JORGENSEN J H, FERRARO M J. Antimicrobial susceptibility testing: a review of general principles and contemporary practices[J]. Clinical Infectious Diseases, 2009, 49(11): 1749-1755.DOI:10.1086/647952.
[24] GOHIL P, NANAVATI B, PATEL K, et al. Assessing the efficacy of probiotics in augmenting bovine reproductive health: an integrated in vitro, in silico, and in vivo study[J]. Frontiers in Microbiology, 2023,14: 1137611. DOI:10.3389/fmicb.2023.1137611.
[25] SUHARSONO H, SUARDANA I W, PINATIH K J P. Bacteriocin potency test of lactic acid bacteria (LAB) isolated from rumen of Bali cattle against low pH and bile salt[J]. Bali Medical Journal, 2022,12(1): 1142-1146. DOI:10.15562/bmj.v12i1.4305.
[26] 童钰琴, 李姝, 牛曼思, 等. 苦荞麸皮总黄酮体外抗氧化活性及体内解酒护肝作用[J]. 食品工业科技, 2020, 41(17): 314-319; 326.DOI:10.13386/j.issn1002-0306.2020.17.053.
[27] GU Z G, GU L, EILS R, et al. Circlize Implements and enhances circular visualization in R[J]. Bioinformatics, 2014, 30(19): 2811-2812. DOI:10.1093/bioinformatics/btu393.
[28] 苏志国, 陈吕军, 温东辉. 环境耐药组及其健康风险的宏基因组学研究策略和方法[J]. 微生物学通报, 2023, 50(4): 1538-1558.DOI:10.13344/j.microbiol.china.221252.
[29] CHAI J J, KORA G, AHN T H, et al. Functional phylogenomics analysis of bacteria and Archaea using consistent genome annotation with UniFam[J]. BMC Evolutionary Biology, 2014, 14: 207.DOI:10.1186/s12862-014-0207-y.
[30] 景秀清, 赵鹏宇, 白雪, 等. 谷田土壤中细菌群落对铬胁迫的响应特征[J]. 农业环境科学学报, 2023, 42(6): 1294-1304. DOI:10.11654/jaes.2023-0192.
[31] GALPERIN M Y, KRISTENSEN D M, MAKAROVA K S, et al.Microbial genome analysis: the COG approach[J]. Briefings in Bioinformatics, 2019, 20(4): 1063-1070. DOI:10.1093/bib/bbx117.
[32] DRULA E, GARRON M L, DOGAN S, et al. The carbohydrate-active enzyme database: functions and literature[J]. Nucleic Acids Research,2022, 50(D1): D571-D577. DOI:10.1093/nar/gkab1045.
[33] SUN Y, LI H C, ZHENG L, et al. iProbiotics: a machine learning platform for rapid identification of probiotic properties from wholegenome primary sequences[J]. Briefings in Bioinformatics, 2022,23(1): bbab477. DOI:10.1093/bib/bbab477.